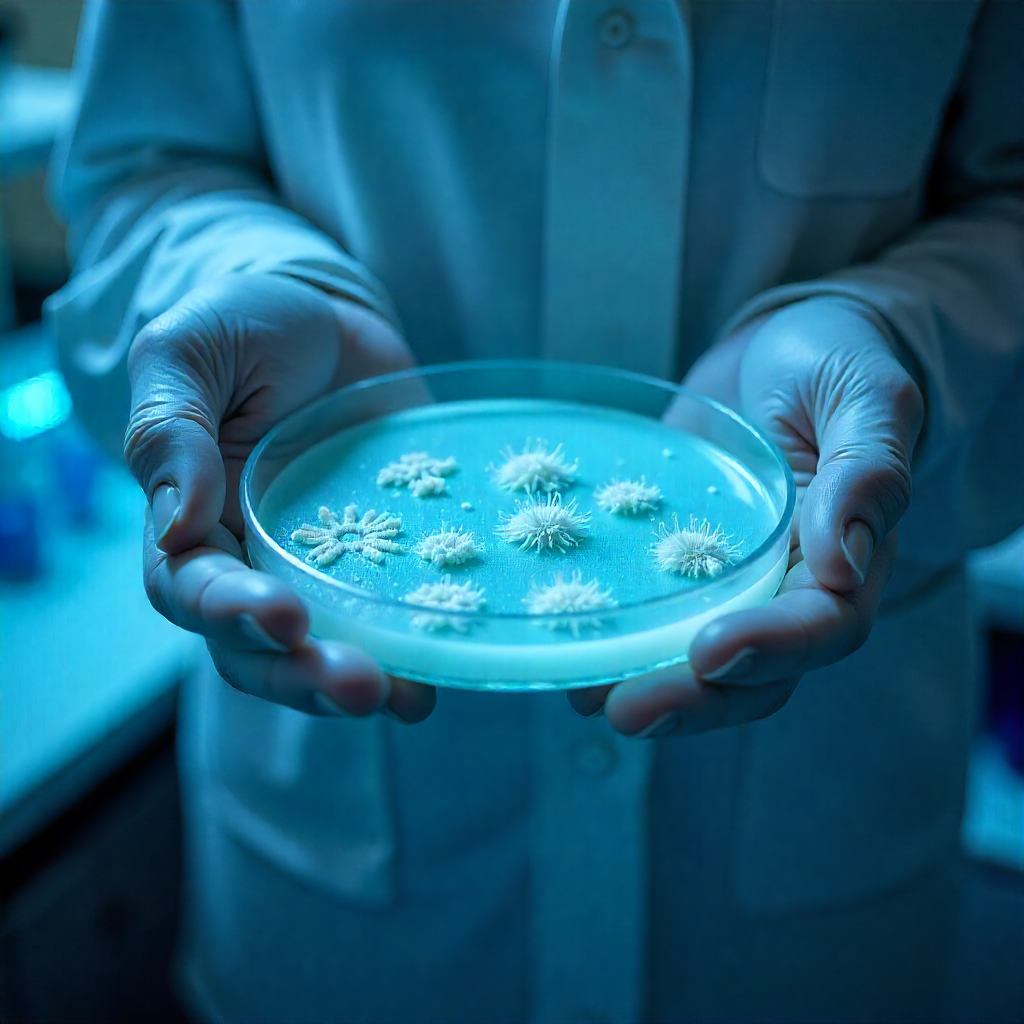
Rationale for Objectionable Microorganisms

This is the fourth in a series of Memos on bioburden issues. It covers the rationale for addressing objectionables as part of a cleaning validation program. Here is what is said in the USA Code of Federal Regulations for drug products. There are similar equivalent statements in regulations for other countries.
21 CFR 211.113(a) “Appropriate written procedures, designed to prevent objectionable microorganisms in drug products not required to be sterile, shall be established and followed.”
21 CFR 211.165(b) “There shall be appropriate laboratory testing, as necessary, of each batch of drug product required to be free of objectionable microorganisms.”
Here are key points to consider relating to these CFR statements.
There is also an FDA Q&A on CGMP as follows. Note that this document is a non-binding recommendation.
Question: 20 “Do pharmaceutical manufacturers need to have written procedures for preventing growth of objectionable microorganisms in drug products not required to be sterile? What does objectionable mean anyway?”
Answer: “Yes, CGMP regulations do require these written procedures. 21 CFR 211.113(a) specifies that appropriate written procedures be established and followed to prevent growth of objectionable microorganisms in drug products not required to be sterile. Even though a drug product is not sterile, a firm must follow written procedures that proactively prevent introduction and proliferation of objectionable microorganisms. … The meaning of the term objectionable needs to be evaluated on a case-by-case basis by each drug manufacturer. The primary meaning relates to microbial contaminants that, based on microbial species, numbers of organisms, dosage form, intended use, patient population, and route of administration, would adversely affect product safety. Microorganisms may be objectionable for several reasons; for example, they:
It may be theoretically possible to try to jump on the difference between the recommendation in the Q&A document where the terminology is slightly different. The issue in the Q&A is the prevention of growth of objectionables and not just the presence of objectionables in the drug product. I would not go too far with this difference in wording, It should make no practical difference, particularly in light of the list of what makes a microorganism objectionable. It is not just the list of possible adverse safety effects of the microorganism in the drug product, but also the level (“number of organisms”), dosage form, intended use, patient population and route of administration.
What about objectionables in API (drug substance) manufacture? Here is what is said in section 11.13 of ISO Q7 (generally considered the worldwide GMPs for APIs).
11.13 “If the API has a specification for microbiological purity, appropriate action limits for total microbial counts and objectionable organisms should be established and met.”
5.23 “Where equipment is assigned to continuous production or campaign production of successive batches of the same intermediate or API, equipment should be cleaned at appropriate intervals to prevent build-up and carry-over of contaminants (e.g., degradants or objectionable levels of micro-organisms).”
Section 20 Glossary ‘Bioburden”
“The level and type (e.g., objectionable or not) of micro-organisms that can be present in raw materials, API starting materials, intermediates or APIs. Bioburden should not be considered contamination unless the levels have been exceeded or defined objectionable organisms have been detected.”
Much like the concern for objectionables in drug products, the concern here is an objectionable in the API itself (or as given in the glossary definition, this may apply to starting materials and intermediates). However, a possible implication of the 5.23 statement is that is that “objectionables” should be part of the evaluation of cleaning process. Note that this statement is formally applicable to “continuous production” or “campaign production”; furthermore, while the term “objectionable” is used, it seems to be limited to objectionable levels and not to objectionable species.
What about objectionables in sterile products? As previously suggested, any microorganism in a sterile product should be considered objectionable regardless of the species. What should be done in cleaning program for a sterile facility is to make sure that any microorganism left on cleaned equipment surfaces is effectively eliminated by either (a) subsequent validated sanitation steps (such as SIP) before actual product manufacture or (b) validated terminal sterilization of the manufactured product. Identification of any microorganism found following the cleaning process is useful because it may lead to steps taken to eliminate the found species prior to equipment SIP or prior to terminal sterilization of the product.
As one moves from addressing the rationales for addressing objectionable microorganisms in a cleaning validation program to actually deciding on how to implement such as program, it is critical that this involves input from a cross-functional team, including microbiologists, production/manufacturing, validation, quality assurance, and medical experts. The first step should be identifying objectionable species in manufactured products, and then working backward to identify how microorganisms in cleaned equipment could be present in products manufactured with that cleaned equipment. The specified microorganisms that should be absent in a drug product as given in USP <1111> are just a starting point before the reasons given in the FDA Q&A documents are addressed. The identification of “objectionable” species may be followed by improvements in the cleaning process to make sure those species are not found on cleaned equipment surfaces such that subsequently manufactured products might truly contain objectionable microorganisms.
Copyright © 2025 by Cleaning Validation Technologies